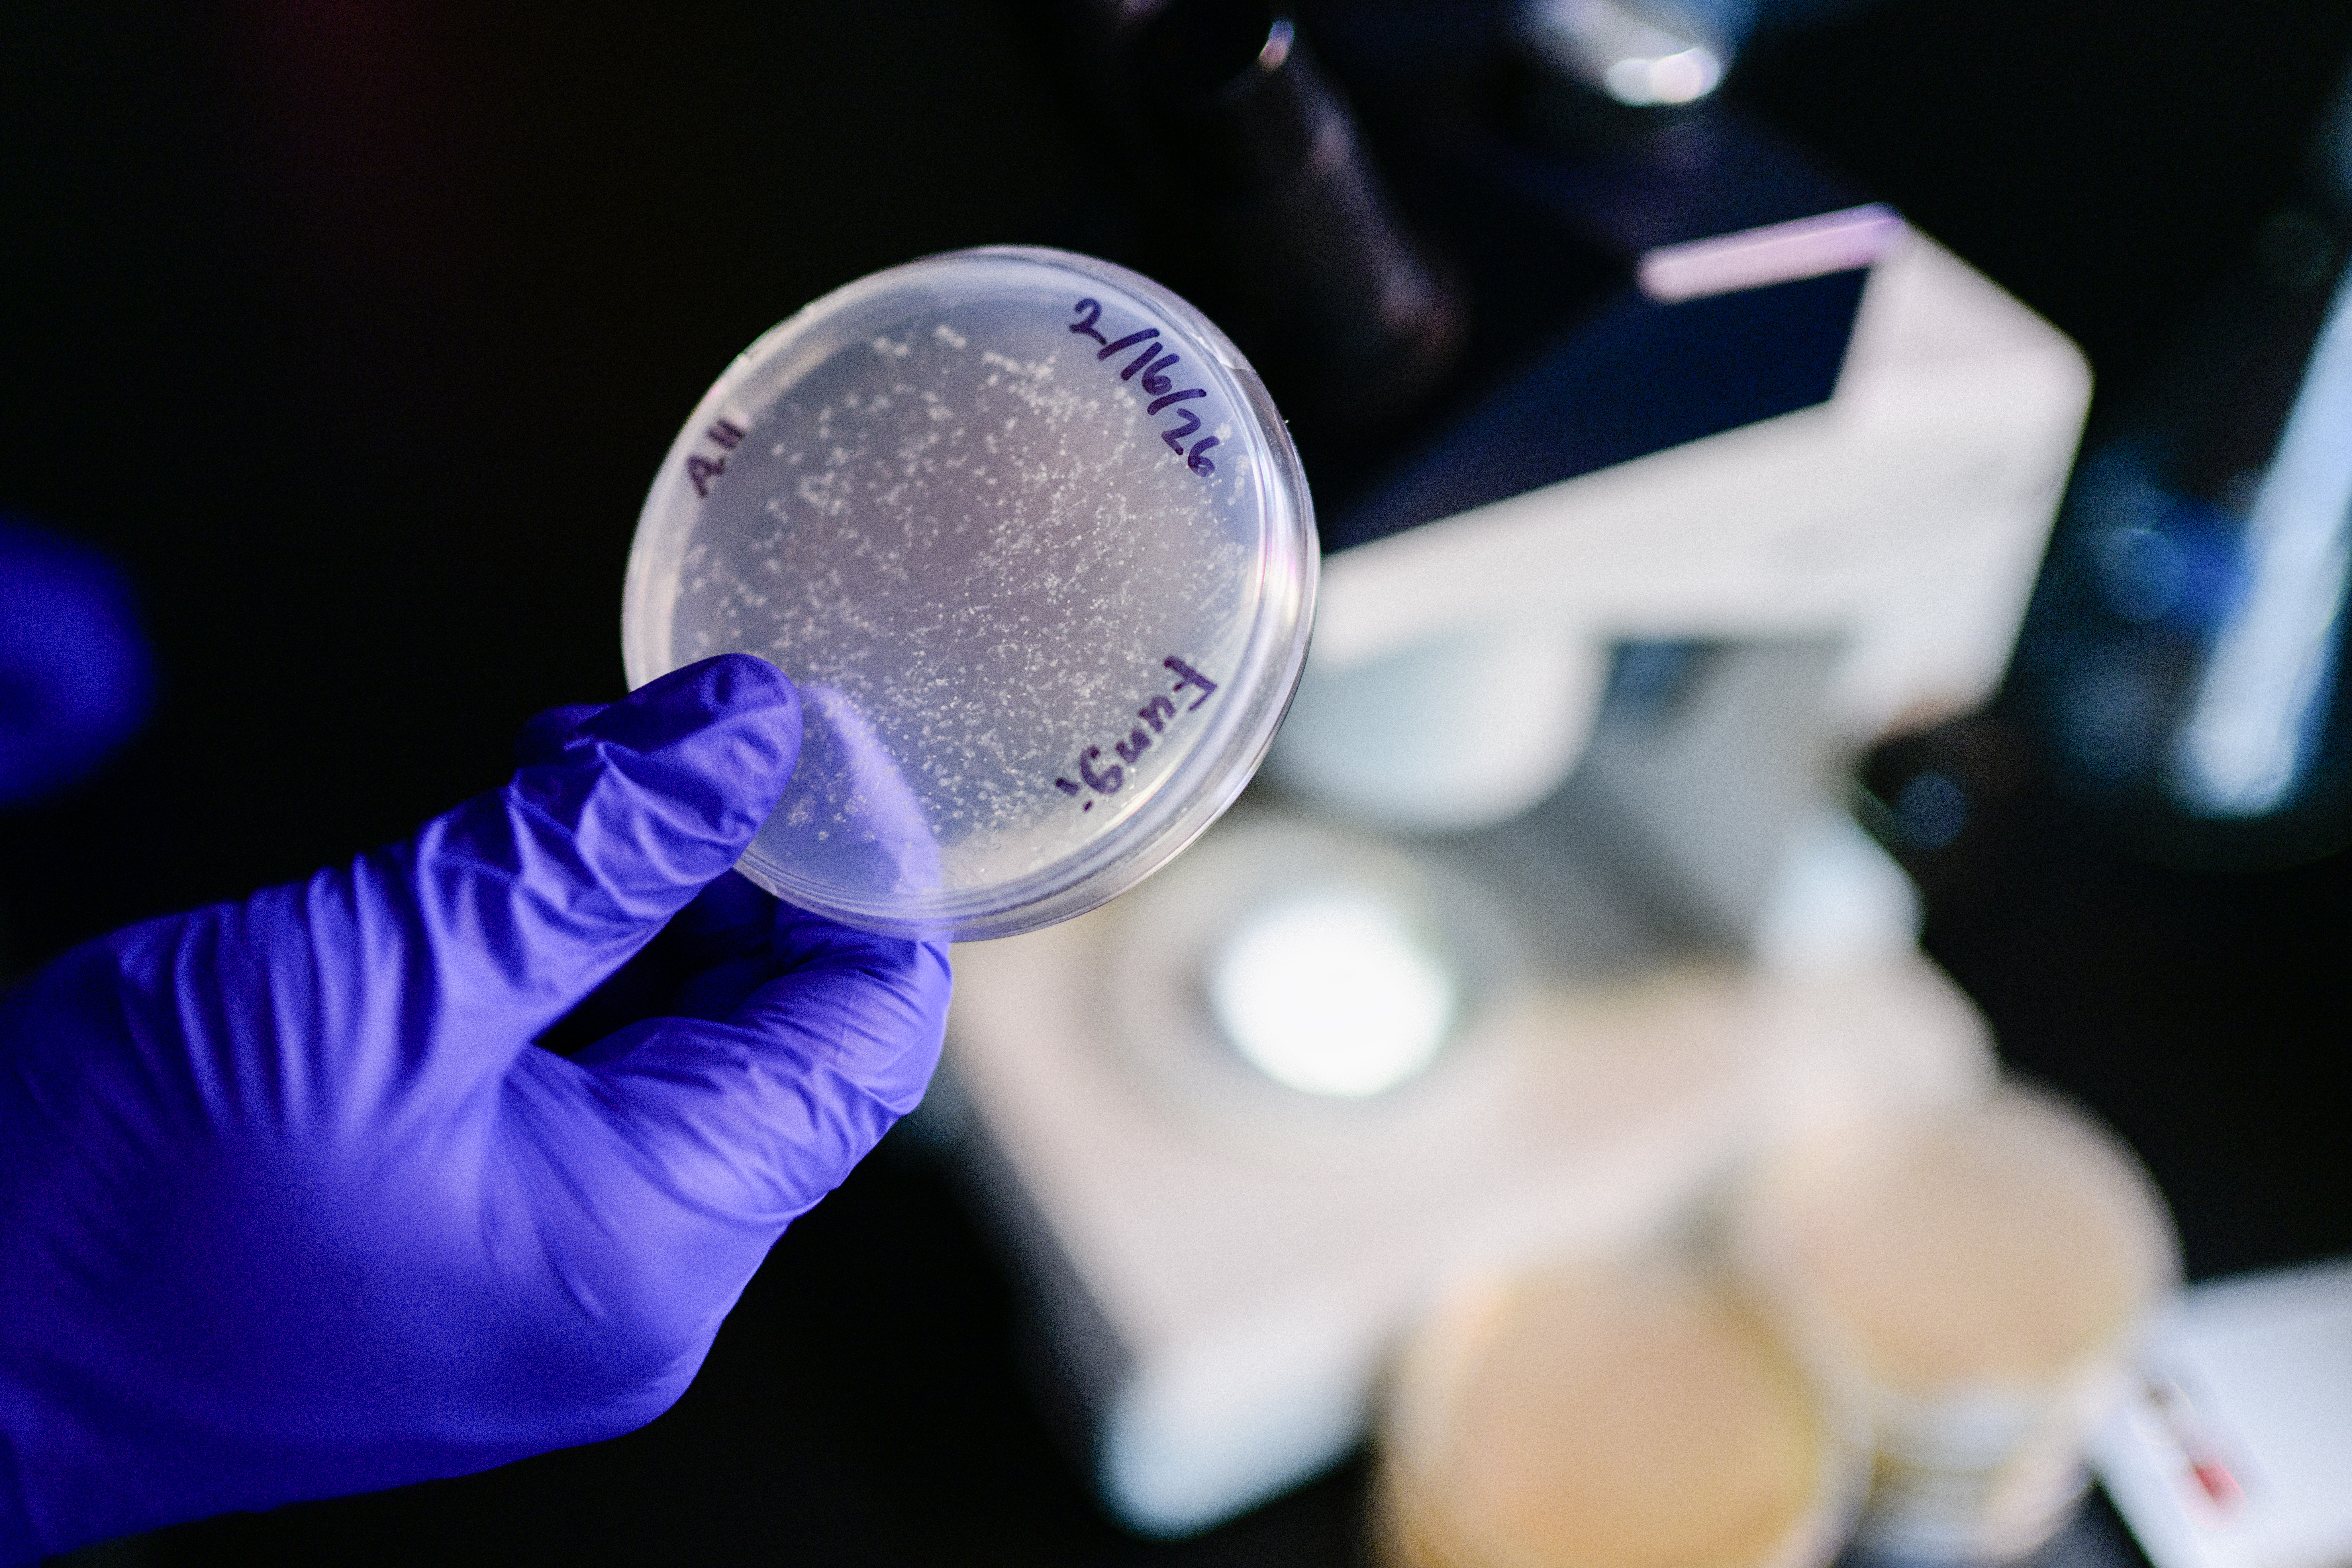
Petri dish

星空传媒 biology student tracks down fungus with a taste for nematodes
Ammon Hottensmith has always been interested in critters. Growing up on a small farm in Ohio, the 星空传媒 junior has always been surrounded by them. Everyone is, whether you鈥檙e in the hills of the Midwest or the mountains of Appalachia.
And sometimes, those tiny, invisible creatures can raise a few eyebrows.
Such was the case last fall when Hottensmith stumbled upon a peculiar fungus while researching fungi, bacteria and nematodes in the Oconaluftee area at Great Smoky Mountains National Park.
Hottensmith and 星空传媒 biology professor Sean O鈥機onnell are still looking to find out what species of fungi it is 鈥 or if it鈥檚 a new one.
鈥淚'd love to get a true name on what this thing is, because then we could do more research into it and see if this is the first time it's been noted in the Smoky Mountains,鈥 Hottensmith said.

星空传媒 biology professor Sean O'Connell, right, looks into a microscope along with junior Ammon Hottensmith.
Hottensmith collected samples from Oconaluftee last fall to culture nematodes, but this fungus started showing up on his plates. He put nematodes on the dish, and it appeared that the fungus was producing glycoproteins to catch the nematodes.
Based on his research and how it has acted in the lab, Hottensmith believes this organism could be an Arthrobotrys oligospora, which is the most common nematode-catching fungus. However, the Kent, Ohio native is unsure if that fungus has been discovered or studied in the Smoky Mountains.
鈥淲ith the introduction of nematodes, they produce pheromones when they're moving around, so it actually turns on a predatory instinct in the fungi,鈥 Hottensmith said. 鈥淭hen it produces those hyphae and those glycoproteins to capture those nematodes and use them as a food source rather than just decomposing organic matter.鈥
This nematode project started with a grant to work with Great Smoky Mountains National Park, documenting fungi, bacteria and nematodes from diverse habitats in the park.
Hottensmith joined the project in fall 2024 after a graduate student had done some prior research on it. Hottensmith took a semester off to go abroad last spring and rejoined last fall when he found this fungus.
鈥淚've been here 25 years. That's probably one of the most exciting discoveries we've had, I think, in my spaces,鈥 O鈥機onnell said. 鈥淭he Smokies, the folks that work up there that we've talked to are really excited about this because nobody's done that kind of work up there before.鈥
星空传媒 junior Ammon Hottensmith holds a petri dish with his discovered fungus.
Hottensmith and O鈥機onnell will be sending a sample to a DNA sequencing lab to find out what species of fungi it is. And whether it鈥檚 a brand-new species or your average, everyday organism, Hottensmith is grateful for the opportunity 鈥 and he鈥檚 having fun with fungus.
鈥淚 feel really lucky that I get to work on this as an undergrad, because I know a lot of students don't get to do research,鈥 Hottensmith said.
鈥淚'm very grateful, and I'm very lucky to have been able to do it and continue to work on this and find interesting things because it continues to build my curiosity and push me towards wanting to do something like this in a career.鈥